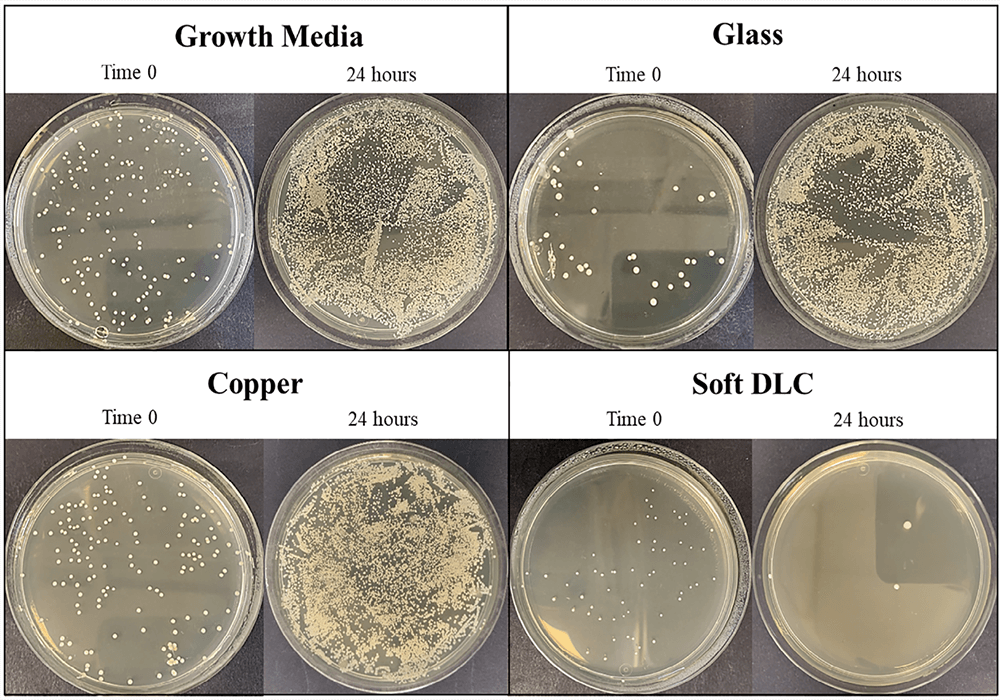
Concurrent Biocompatibility and Antimicrobial Functionality

Published research and process guides
Applications library
Explore Moorfield application notes by research area, material system or process. Search for a topic, filter by grouped category, and connect published examples to relevant product platforms.
Evidence-led selectionUse publication examples to understand how thin-film and plasma tools are applied in real research workflows.
Grouped by research themeBrowse sensors, energy, photonics, materials, 2D materials, process guides and device research.
Connected to platformsMove from application evidence to the product family or selector workflow that best fits your process needs.
No matching applications found. Try a broader material, process or application term.
Need help translating an application into a system choice?
Use the selector or contact Moorfield with your material system, substrate size and process approach.
Example Applications
Learn how our thin film deposition, plasma etching and anneal products play a key part in real-world applications and cutting-edge research.